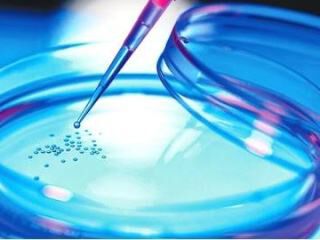

读创科技 2018/09/20 19:11
读创/深圳商报记者 王海荣 文/图
细胞治疗技术正向质量型发展,加强创新技术产业化中间能力建设备受关注。
9月20日,2018深圳国际BT领袖峰会和生物/生命健康产业展览会在深圳会展中心举行。当天下午举行的创新技术产业化中间能力建设论坛上,专家呼吁加强标准建设,推动细胞产业健康发展。

本次论坛由深圳市人民政府和科技部中国生物技术发展中心等单位指导,深圳市发改委、深圳市科创委和深圳市科协等单位联合支持,由深圳市科技开发交流中心联合个体化细胞治疗技术国家地方联合工程实验室、深圳市北科生物科技有限公司等单位共同主办。深圳市政协主席戴北方,深圳市政府副秘书长吴优,深圳市委卫生工委专职副书记、委党组成员廖澍华,深圳市市场和质量监督管理委员会党组成员、机关党委书记、深圳市市场监督管理局(市质量管理局、市知识产权局)副局长夏昆山,深圳市发展和改革委员会副主任蔡羽,深圳市科学技术协会党组成员、副巡视员孙楠等出席了当天的会议。
作为2018深圳国际BT领袖峰会的重要组成部分,创新技术产业化中间能力建设论坛邀请了全球生物技术领域知名学者,以个体化细胞治疗技术的产业化中间能力建设为切入点,围绕生物医药、生命健康领域创新技术产业化面临的机遇和挑战展开热议。

深圳生物医药产业星光熠熠
生物医药产业是深圳市重点发展的战略性新兴产业之一,目前已经形成了扎实的产业基础。
从2009年开始,深圳重点打造生物医药产业集群,出台了生物产业振兴发展规划及配套政策,2013年出台了生命健康产业发展规划和深圳国际生物谷总体发展规划。近年来,深圳生物医药产业年均增长均超过10%。今年上半年,深圳生物医药产业增加值141.92亿元,增长23.8%,在深圳七大战略性新兴产业中增幅居首。
据了解,2017年深圳生物医药产业规模超过2400亿元,高端生物医学工程、基因测序和生物信息分析、细胞治疗等技术跻身世界前沿,生物医药产业快速发展已成为深圳经济增长新动力,从中也涌现出了一大批代表性企业,其中作为我国生物治疗技术临床转化领军企业的北科生物是深圳市战略性新兴产业的重要代表,也是深圳市构建发展个体化细胞治疗“创新链+产业链”的重要参与方。通过多年深耕前沿细胞技术领域,北科生物已经布局个体化细胞治疗临床研究转化技术支持网络,拥有个体化细胞技术领域相关专利82项,承担了国家、省、市等各级政府相关科技项目60余项,其中6项属于国家级项目。
细胞产业标准建设正当其时
在生物医药产业中,细胞治疗技术正成为全球医学研究的热点课题。本届创新技术产业化中间能力建设论坛上,专家建议要加快标准建设,推动细胞治疗技术在保障人类健康方面的应用。
“标准建设是细胞产业发展的关键,推动行业标准化建设正当其时。”中国标准化研究院书记兼副院长王宗龄指出,目前国内生物技术等许多新兴产业存在标准缺失、标准化工作基础薄弱等问题。她建议从机构设置、基础研究、标准建立、人才培养等方面发力,同时发挥政策导向作用,走“技术专利化、专利标准化、标准产业化、标准国际化”的创新路线,用“科技+标准”优化监管,从而全面提升生物技术标准化建设水平。
中国科学院动物研究所干细胞与生殖生物学国家重点实验室干细胞与免疫学研究组组长兼中国科学院大学岗位教授赵同标在谈到干细胞标准化研究时表示,干细胞虽然为治疗多种“不治之症”带来希望,但由于免疫配型以及细胞来源不一、作用各异、评价复杂等原因,导致质量控制困难等因素,使干细胞规模化生产和临床应用面临巨大困境。
他认为,如何规模化制备针对特定适应症治疗用细胞,确定针对干细胞生物学特性、安全性、有效性和稳定性等基本问题的质控标准,是当前干细胞临床应用亟待解决的关键问题。其中,干细胞标准化的建设在我国干细胞转化研究和应用的规范化方面起着重要的推进作用。
中国质量认证中心体系认证管理部首席专家和高级工程师李明指出,要加快干细胞产业标准体系与过程认证,推动相关产业健康发展。
位于深圳南山的个体化细胞治疗技术国家地方联合工程实验室是国家发改委于2015年批复成立的独立法人主体,该实验室致力于一系列细胞领域从实验室成果向临床工具转化的中间能力建设,形成保障细胞技术由“实验结果”升级为“临床工具”的工业化工艺开发能力和质量体系,促进个体化细胞治疗技术向临床治疗工具转化。
“我们还将同时致力于行业技术标准的建立,联合国内、国际先进的标准组织和行业协会,基于细胞的药品属性,促进细胞发展成为大规模、低成本、可复制、高质量的先进制造业。”实验室主任刘沐芸说。
创新技术推动产业发展
生物医药、生命健康是一个创新技术层出不穷的领域,本次创新技术产业化中间能力建设论坛上也展示了多项新技术。
来自美国医学与生物工程院院士兼丹纳赫公司贝克曼库尔特生命科学事业部首席技术官陈永勤针对免疫疗法、细胞疗法和细胞外倍体研究的需求,着重介绍了近年来多参数、高灵敏度流式细胞仪的现状和发展趋势。
陈永勤介绍,流式细胞仪作为生物技术、计算机科学、激光技术、分子生物学、微电子学和光电技术等学科知识交叉的结晶,在细胞生物学、临床医学和新药开发上有着广泛的应用。
卫生部临床检验中心研究员王露楠介绍了输血医学及血筛检测的最新技术发展。
欧洲学术研究院院士兼德国科学院院士洛萨·威尔米策和与会者探讨了生命科学中的一项重要技术——代谢组学。他认为,代谢处于所有生命生物机能的中心地位,反映着生物体在不同环境下的状态。与稳定的基因相比,代谢将遗传信息与环境和发育的多种影响整合在一起,并分析代谢与人体状态之间的相关性,可研发不同的诊断方法。
据介绍,洛萨·威尔米策开发的代谢组学技术可高通量地分析代谢物,这些数据可以用于特异性地识别特定的疾病模式。与机器学习相结合后,还能应用于疾病诊断。
读创编辑李耿光